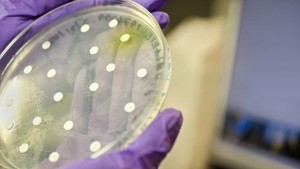
Ще откриват престъпници по уникалните за тях бактерии

Технологии
Актуални новини от Технологии. Посетете нашата секция с новини от Технологии Сега!
10.09.2014
Американската компания печата електромобил на 3D принтер
Американската компания Local Motors е започнала отпечатването на 3D принтер на електромобил ...
09.09.2014
Apple представи iPhone 6 и iPhone 6 Plus
Американският технологичен гигант Apple (Епъл) организира събитие в Купертино, Калифорния, ...
09.09.2014
Хигс бозонът може да доведе до апокалипсис, вещае Стивън Хокинг
Известният физик-теоретик и космолог Стивън Хокинг предсказва апокалипсис, който ...
09.09.2014
Култовите сериали в каналите на Нова - достъпни и в Nova Play
Култовите сериали в каналите на Нова телевизия вече са достъпни и в системата на Nova ...
09.09.2014
НАСА разработва подводница за изследване на космически океани
НАСА разработва космическа подводница за изследването на океанските води на една ...
09.09.2014
Откриха угаснал вулкан в дълбините на Тихия океан
Подводна планина бе открита по време на експедиция с американски кораб за океански ...
08.09.2014
Нова карта на океаните посочва виновниците за островите от боклук
Учени от университета на Нов Южен Уелс създадоха нов атлас на световните океани, който ...
08.09.2014
Китай изстреля два изкуствени спътника
Китай успешно изведе в орбита изкуствените спътници на Земята "Яоган-ХXI" и "Тянто-1", ...
08.09.2014
Приставка ни помага никога да не губим очилата си
Израелската изобретателка Дафна Ариели конструира специална приставка, която помага ...
08.09.2014
Луна на Юпитер има тектонични плочи като Земята?
Покритата с лед Европа - една от луните на Юпитер, може би е изградена от система от ...
06.09.2014
Преброиха езерата на Земята
Шведски и естонски учени преброиха за пръв път всички езера на Земята - оказа се, че ...
05.09.2014
Учени осъществиха телепатична връзка
Учени успяха да изпратят просто умствено съобщение от един човек в Индия до друг във ...
05.09.2014
Астероид ще премине безопасно край Земята в неделя
Новооткрит астеорид ще премине край Земята в неделя вечерта на разстояние 10 пъти по-близко ...
04.09.2014
Смарт клечки за хранене разкриват опасни продукти
В Китай, където често възникват хранителни скандали, интернет гигантът Байду разработи ...
04.09.2014
Млечният път обитава огромен галактичен комплекс
Галактиката Млечен път обитава покрайнините на неизвестен досега масивен галактичен ...
04.09.2014
Конструираха тоалетна чиния, която разсейва лошите миризми
Американски рационализатор конструира тоалетна чиния, оборудвана с вентилаторче, ...
03.09.2014
Руски учени създадоха биоизкуствен черен дроб
Руски учени създадоха биоизкуствен черен дроб на базата на клетъчна технология. "В ...
03.09.2014
Александър Варов стана част от семейството на „Нетинфо“
Александър Варов се присъединява към голямото семейство на „Нетинфо" на позиция „Портфолио ...
03.09.2014
Полярните вихрушки са резултат от топенето на морския лед
Ново изследване показва, че със затоплянето на планетата студени маси въздух по-често ...
03.09.2014
Google търси пътя към изкуствения интелект
Компанията Google ("Гугъл") работи по супербърз "квантов" компютърен чип, като част от виждането ...
02.09.2014
Учени получиха гориво с помощта на бактерии Е. коли
Британски и финландски учени получиха пропан, като използваха бактерия, характерна ...
02.09.2014
Кутийка за годежен пръстен изтласква бижуто като цъфтящо цвете
Канадски дизайнер е конструирал уникална кутийка за годежен пръстен с дебелината ...
01.09.2014
Космическо уиски се завръща на Земята
Шотландско уиски, изстреляно в космоса преди три години, ще се завърне на Земята следващата ...
01.09.2014
Конструираха "обратен" чадър, нарекоха го Казбрела
Британски рационализатор конструира "обратен чадър", който се отваря на обратно и издутата ...
01.09.2014
Разработиха молекула, ефикасна в борбата с болестта на Алцхаймер
Три френски лаборатории в Кан и Монпелие оповестиха, че са открили молекула, която ...
01.09.2014
Учени ще записват всеки звук на Земята
Изследователи ще записват всеки звук, издаван на Земята - от песните на птиците през ...
31.08.2014
Ще откриват престъпници по уникалните за тях бактерии
Хората оставят върху различни предмети не само пръстовите си отпечатъци, но и някои ...
29.08.2014
Безпилотен самолет на Google достави шоколад на австралийски фермер
Австралийски фермер е получил първата пратка на Google (Гугъл), изпратена с безпилотен ...
29.08.2014
Разгадаха тайната на движещите се камъни в Долината на смъртта
Години наред учените теоретизират как големи камъни - някои от които с тегло десетки ...
29.08.2014
Германец измисли "пицакоптер"
Германец измисли летяща кутия за пици с дистанционно управление, съобщи в. "Дейли телеграф".
За ...
28.08.2014
Конструираха презерватив за USB
Нюйоркски експерти по компютърна сигурност конструираха "презерватив" за USB, който ...
28.08.2014
Учени надникнаха в душата на Слънцето
Учени успяха за пръв път да наблюдават слънчевото ядро, проследявайки неговите емисии ...
27.08.2014
Учени създадоха гъвкави слънчеви батерии
Учени от Корейския електротехнически научно-изследователски институт създадоха първите ...
27.08.2014
Астрономи за пръв път откриха водни облаци извън Слънчевата система
Астрономи обявиха, че вероятно са открили за пръв път водни облаци извън Слънчевата ...
25.08.2014
Вече има пет възможни места за първото кацане върху комета
Европейската космическа агенция е съставила списъка с петте възможни места за първото ...
25.08.2014
Миниатюрен имплант предвещава края на очилата
Учени разработиха миниатюрен имплант - колкото глава на карфичка, който се поставя ...
25.08.2014
Стъклена сфера е с 35% по-ефикасна от слънчевите панели
Германският архитект Андре Брьосел проектира устройство, което може да концентрира ...
25.08.2014
Учени произвеждат биоразтворима пластмаса от ориз и спанак
В бъдеще хората ще полагат морни тела на столове от ориз или спанак благодарение на ...
24.08.2014
Комисия ще разследва отклоняването на спътниците „Галилео” от орбита
Компания „Арианспейс” - оператор на космодрума Куру във Френска Гвиана, откъдето ...
24.08.2014
Смарт клавиатура разчита настроенията ни по ударите върху клавишите
Програмисти от Ислямския технологичен университет в Дака, Бангладеш, са разработили ...